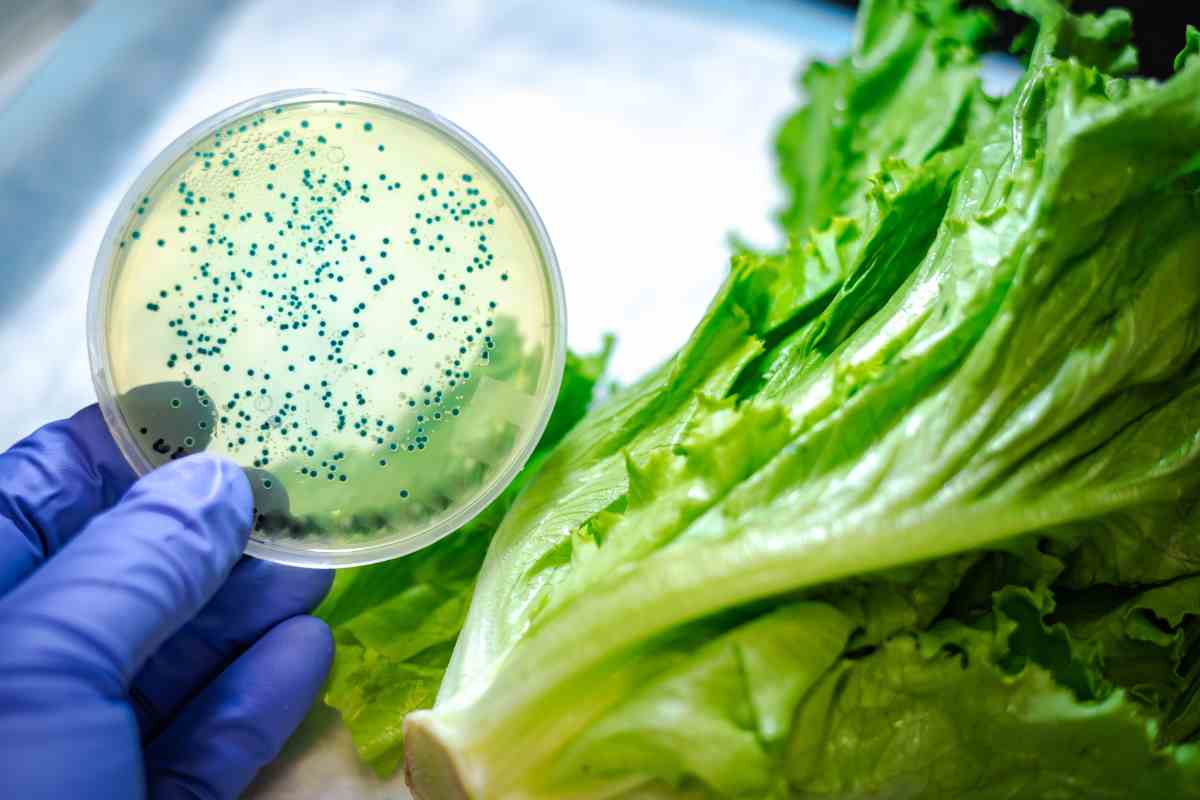
Richiamo alimentare, attenzione a questa spezia comunissima

Attenzione a questo nuovo trucchetto che scattano 1382 euro: tutti i dettagli e le curiosità…
Antonella Boccasile
Compagnie aeree meno sicure al mondo, non tutti lo sanno ma i dati non mentono:…
Se vuoi vivere da Re con meno di 400 euro questa è la soluzione per…
Attenzione alla nuova truffa del caffe, dove basta un attimo per svuotarti il conto: ecco…
Risparmi benzina e soldi, dove i mezzi pubblici costano meno in Europa: ci sono anche città italiane
Se vuoi risparmiare soldi di benzina, ecco i mezzi pubblici che costano meno in Europa:…
Città meno care d'Italia oltre Milano, ecco quali sono: tutti i dettagli e le curiosità…
Addio alle vecchie tende, la soluzione più cool del momento che ti fa risparmiare è…
Se vuoi dare un tocco di innovazione alle tue pulizie, prova questo super prodotto LIDL:…
Se ti trasferisci in questo Comune potresti avere 2000 euro: questa è l'occasione per te,…
Attenzione a questo prodotto presente sempre nelle vostre cucine: se lo avete comprato buttatelo subito,…
Se lavori in smartworking, queste sono le città con gli affitti più bassi dove vivere…
Aria condizionata, se emana un cattivo odore anche dopo aver lavato i filtri, questo è…